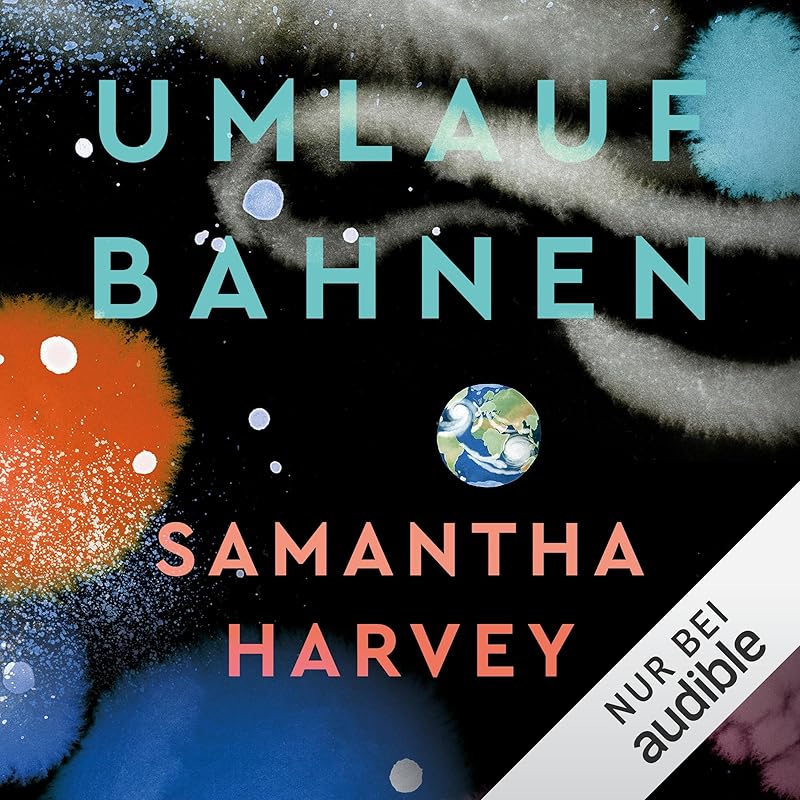
cover-image

Am Abend des 12. November blickte die internationale Buchbranche nach London. In der englischen Hauptstadt lud die Booker Prize Foundation zum feierlichen Dinner, um bekanntzugeben, wer in diesem Jahr Englands wichtigsten Literaturpreis erhält. Die Veranstaltung fand mit ein paar hundert geladenen Gästen im Gebäude des Old Billingsgate Market statt und wurde simultan im Live-Stream auf Youtube übertragen. Als Jury-Vorsitzender Edmund de Waal auf die Bühne trat, um zu verkünden, welcher Roman den mit 50.000 britischen Pfund – umgerechnet etwa 59.800 Euro – dotierten Preis erhält, spannte er das Publikum zunächst mit einem dreiminütigen Plädoyer für die Literatur als Mittel zur persönlichen Horizonterweiterung auf die Folter, um dann lakonisch zu verkünden:
„Es ist mir eine große Ehre bekanntzugeben, dass die Gewinnerin des Booker Prize 2024 Samantha Harvey mit ‚Orbital‘ ist.“
Auf diese Ansage folgten eine gute Minute frenetischer Applaus und die Dankesrede einer sichtlich überwältigten Preisträgerin. Samantha Harvey hatte bereits 2009 mit ihrem Roman „The Wilderness“ auf der Longlist für den Booker-Prize gestanden. Mit Orbital hat sie nun das Rennen gemacht. Der Roman ist eine poetische Weltraumballade, in der zwei Astronautinnen und vier Astronauten auf einer Mission ins All nicht nur an ihre eigenen Grenzen stoßen, sondern sich auch der Schönheit des Universums und des Planeten Erde bewusst werden. In deutscher Übersetzung ist das Buch vor Kurzem unter dem Titel „Umlaufbahnen" erschienen.
Ihre Dankesrede verband Samantha Harvey mit einem dringlichen Appell für die menschliche Würde und die Erhaltung unseres Planeten. „Ich denke, keine Booker-Dankesrede wurde je in einer perfekten Welt gehalten, aber es ist unmöglich eine zu halten, ohne die Mängel der Welt zu erwähnen, in der wir genau jetzt leben", sagte sie. „Wir sind – wie Carl Sagan es in seinem Buch ‚Cosmos‘ ausdrückt – ‚die irdische Verkörperung eines Bewusstseins, das zu Selbstbewusstsein herangewachsen ist. Wir sind Sternenstaub, der über die Sterne nachdenkt.‘ Dem möchte ich anfügen, dass wir ebenso Erdstaub sind, der über die Erde nachdenkt. Ich denke, mein Roman ist eine Übung für dieses Nachdenken."
Samantha Harvey bringt die Grundidee von Orbital mit einem starken Bild auf den Punkt. „Die Erde aus dem Weltraum zu betrachten, ist vergleichbar mit einem Kind, das in den Spiegel blickt und zum ersten Mal wahrnimmt, dass die Person im Spiegel sie selbst ist", sagte die Autorin in ihrer Booker-Rede. „Was wir der Erde antun, tun wir auch uns selbst an. Und auch was wir dem Leben auf der Erde antun – menschlichem und anderen –, tun wir uns selbst an."
Folgerichtig schloss Harvey – erneut mit Bezug auf Carl Sagan – mit den Worten: „Es ist eine Frage der Loyalität gegenüber unserer Spezies und dem Planeten, sagt Sagan, dass wir uns für die Erde einsetzen. Aus diesem Grund möchte ich diesen Preis all denen widmen, die für und nicht gegen die Erde eintreten, für und nicht gegen die Würde anderer Menschen und anderen Lebens – all jenen Leuten also, die für Frieden einstehen, argumentieren und arbeiten. Dieser Preis ist für euch." Auch für diesen Appell erntete die Preisträgerin langen Applaus.
Das All als Schauplatz: Fesselnde Weltraum-Bücher von sachlich bis fantastisch
Was ist der Booker Prize?
Der Booker Prize ist Großbritanniens wichtigster Literaturpreis. Einmal jährlich würdigt er „das beste nachhaltige Romanwerk, das in englischer Sprache verfasst und im Vereinigten Königreich und Irland veröffentlicht wurde“. Er wurde in diesem Jahr zum 55. Mal vergeben.
Ins Leben gerufen wurde der Preis 1969 von den Verlegern Jock Campbell, Charles Tyrell und Tom Maschler. Nach dem Vorbild des Prix Goncourt, der bereits seit 1903 Maßstäbe für die französische Literatur setzte, wollten die Drei auch für die englischsprachige Belletristik einen Preis etablieren, der zu Debatten über zeitgenössische Bücher anregt. Das ist ihnen gelungen.
Heute charakterisiert die für die Vergabe des Preises zuständige Booker Prize Foundation die Trophäe selbstbewusst als „weltweit einflussreichste Auszeichnung für einen einzelnen Roman“. Nicht ohne Grund. Bücher, die den Preis in den vergangenen Jahrzehnten bekommen haben, wurden nicht nur im englischsprachigen Raum zu Bestsellern, sondern auch international erfolgreich. So wurden viele ausgezeichnete Titel ins Deutsche übersetzt.
Bücher, die den Booker Prize bekommen haben, auf Deutsch hören
Die Strahlkraft des Booker Prize lässt sich gut am Gewinnertitel des Jahres 2023 verdeutlichen: „Prophet Song“ von Paul Lynch, auf Deutsch unter dem Titel „Das Lied des Propheten“ erschienen. In der Woche nachdem Lynch im November 2023 den Booker Prize für seine in einem dystopischen Irland spielende Familiensaga bekommen hatte, steigerten sich die Verkaufsraten des Romans im Vereinigten Königreich um 1.500 Prozent. Der Hype hielt an. So wurden aus den bis dahin 4.000 verkauften Exemplaren inzwischen über 100.000. Der Erfolg führte zu Übersetzungen in mehr als ein Dutzend Sprachen.
Booker Prize 2024: Welche Bücher standen noch auf der Shortlist?
Für den diesjährigen Booker Prize waren englischsprachige Originalromane zugelassen, die zwischen dem 1. Oktober 2023 und dem 30. September 2024 in einem britischen oder irischen Verlag erschienen sind. Insgesamt wurden der Jury 156 Titel vorgelegt. Jury-Vorsitzender Edmund de Waal, beschrieb das zentrale Auswahlkriterium folgendermaßen:
„Wir wollten Bücher finden, die wichtig sind, Bücher, von denen wir unbedingt wollen, dass andere Menschen sie lesen, den Roman, über den man nicht aufhören kann zu reden.“
Bereits im Juli hatte die fünfköpfige Jury eine Longlist mit 13 Titeln veröffentlicht, von denen die sechs besten die Shortlist erreichten. Im Folgenden lernst du zunächst die weiteren Shortlist-Werke des Booker-Prize-Jahrgangs 2024 kennen, anschließend erfährst du mehr über die Jury und die Longlist.
Booker Prize 2024: Alle Shortlist-Titel auf einen Blick
Titel | Autorin/Autor | Erscheinungstermin | |
1 – Gewinnerin | November 2023 | ||
2 | April 2024 | ||
3 | September 2024 | ||
4 | Januar 2024 | ||
5 | Mai 2024 | ||
6 | Oktober 2023 |
Die fünf Titel von der Booker-Prize-Shortlist, die nicht gewonnen haben, wurden jeweils mit einem Preisgeld in Höhe von 2.500 britischen Pfund, umgerechnet knapp 3.000 Euro. Die Preisgelder werden beim Booker Prize von Sponsoren bereitgestellt, derzeit von der gemeinnützigen Crankstart-Stiftung.
„James“ von Percival Everett
Nachdem die deutsche Übersetzung von Percival Everetts Roman „James“ – eine Neuerzählung der „Abenteuer des Huckleberry Finn“ – in diesem Sommer bereits für den Internationalen Literaturpreis des Hauses der Kulturen der Welt nominiert war, geht das Original nun ins Rennen um den Booker Prize. In dem Roman erzählt Percival Everett die Floß-Odyssee über den Mississippi von Huck Finn aus Sicht von dessen Begleiter – dem der Sklaverei entflohenen Jim alias James.
Für den mehrfach preisgekrönten Autor Percival Everett ist dies das zweite Mal, dass er in die Booker-Prize-Endrunde kommt. Er stand bereits 2022 mit „The Trees“ (erschien auf Deutsch unter dem Titel „Die Bäume“) auf der Shortlist.
Das sagt die Booker-Prize-Jury über James:
„Eine packende Antwort auf Twains Klassiker, die eine kühne Beleuchtung eines düsteren historischen Kapitels und ein Zeugnis der Widerstandsfähigkeit des menschlichen Geistes ist.“
Erfahre mehr über „James“ und weitere Romanneuheiten: Unsere Sommerbücher 2024
„Creation Lake“ von Rachel Kushner
Die Werke von US-Autorin Rachel Kushner sind sichere Bestseller und wurden in der Regel auch ins Deutsche übersetzt (unter anderem liegen von ihr die Romane „Flammenwerfer“ und „Telex aus Kuba“ sowie die Essay-Sammlung „Harte Leute“ vor). In Kushners mit Spannung erwartetem neuen Roman Creation Lake erliegt eine Geheimagentin mit dem vielsagenden Decknamen Sadie Smith den Manipulationskünsten des Öko-Fundamentalisten Bruno Lacombe – eine erschütternde Erfahrung für die Berufszynikerin, die es gewohnt ist, selbst Menschen zu manipulieren.
Auch Rachel Kushner ist nicht zum ersten Mal für den Booker nominiert. Sie stand bereits 2018 mit „The Mars Room“ auf der Shortlist.
Das sagt die Booker-Prize-Jury über Creation Lake:
„Ein unwiderstehlicher Pageturner über eine Auftragsspionin, die eine Umweltaktivismus-Kommune im ländlichen Frankreich unterwandert. Elektrisierend ideenreiche Prosa.“
In geheimer Mission: Unsere Top-Agenten-Thriller
„Held“ von Anne Michaels
Wie kollektive Traumata nachwirken und die Zeit überdauern thematisierte die kanadische Schriftstellerin und Dichterin Anne Michaels schon in ihrem preisgekrönten Roman „Fugitive Pieces“ (auf Deutsch als „Fluchtstücke“ erschienen), in dem sie das bis heute andauernde Leid verhandelte, das jüdischen Menschen durch den Holocaust zugefügt wurde. In Held geht die Autorin noch einen Schritt weiter. Ausgehend vom Schicksal eines Überlebenden des Ersten Weltkriegs beschwört sie wortwörtlich die Geister der Vergangenheit herauf und entfaltet ein gleichermaßen historisches wie poetisches Panorama des 20. Jahrhunderts bis in die Gegenwart.
Held kann als Opus Magnum der Anne Michaels gelten. In einem Interview mit dem kanadischen Radiosender CBC bekannte die Autorin, dass die Arbeit an dem Roman insgesamt 15 Jahre dauerte. Die deutsche Übersetzung erscheint Ende September unter dem Titel „Zeitpfade“ im Berlin Verlag.
Das sagt die Booker-Prize-Jury über Held:
„Ein kaleidoskopischer Roman über Krieg, Trauma, Wissenschaft, Glaube und, vor allem, Liebe und menschliche Beziehungen. Dieses Buch scheint die Gedankenwelt zu verändern.“
Auf den Spuren der Geschichte: Romane über den Zweiten Weltkriege und seine Folgen
„Safekeep“ von Yael van der Wouden
Ein abgelegenes Landhaus in der niederländischen Provinz Overijssel wird in Yael van der Woudens Safekeep zum Schauplatz eines erotischen Thrillers. Im Jahr 1961 muss die spröde Einzelgängerin Isabel unerwartet die neue Freundin ihres Bruders bei sich aufnehmen. Eva ist das genaue Gegenteil der Gastgeberin – laut, schlampig, unzuverlässig. Zunächst reagiert Isabel paranoid auf die neue Mitbewohnerin. Dann verliebt sie sich in sie. Der Beginn einer literarischen Implosion der Realität.
Yael van der Wouden wurde für ihre Essays und Kolumnen bekannt, in denen sie sich forsch und provokant mit ihrer niederländischen, jüdischen und queeren Identität auseinandersetzt. In ihrem ersten Roman lotet sie die fließenden Grenzen von Begehren und Abscheu, Zuneigung und Rache aus.
Das sagt die Booker-Prize-Jury über Safekeep:
„Ein bemerkenswertes Debüt über Obsession und Verlust (...) Die Autorin zieht uns in eine Welt hinein, in der alles so behutsam arrangiert ist wie in einem niederländischen Stillleben.“
Land of Dope and Glory: Unser Check der Gegenwartsliteratur in den Niederlanden
„Stone Yard Devotional“ von Charlotte Wood
Australierin Charlotte Wood erzählt in Stone Yard Devotional von einer Frau aus Sydney, die sich im Kloster Monaro Plains eine Auszeit gönnen will – ein Unterfangen, das deutlich länger dauert und tiefschürfender ausfällt als erwartet. Was auf ersten Blick wie ein klassischer Alltagsflucht-Plot anmutet, wandelt sich im Laufe der Erzählung zu einer philosophischen Auseinandersetzung mit dem Leben als solchem – spirituell, aber nicht esoterisch, todernst, aber mit einer Direktheit, die immer wieder auch Raum für zupackende Komik zulässt.
Charlotte Wood gilt als eine der originellsten und konsequentesten Autorinnen Australiens. In ihren Büchern verbindet sie feministische Standpunkte mit scharfsinnigen Alltagsbeobachtungen und einer guten Prise Lebensweisheit. Nachdem ihr Freundinnen-Roman „Ein Wochenende“ auch in Deutschland zum Bestseller wurde, erschien die deutsche Übersetzung von Stone Yard Devotional im Herbst 2023 zeitgleich mit dem Original unter dem Titel „Tage mit dir“.
Das sagt die Booker-Prize-Jury über Stone Yard Devotional:
„Eine Frau quartiert sich in ein australisches Kloster ein und muss feststellen, dass kein Schutzraum uneinnehmbar ist. Dieser Roman begeisterte und erschütterte die Jury.“
Schwestern der Revolution: Neue feministische Literatur im Fokus
Booker Prize 2024: Die Jury
Die Booker Prize Foundation besetzt das Jury-Team jedes Jahr neu. Es besteht normalerweise aus fünf Personen, die verdiente Größen in den Bereichen Schriftstellerei, Kunst und Literaturkritik sind. So auch in diesem Jahr.
Jury-Vorsitzender ist der Autor und Keramiker Edmund de Waal („Der Hase mit den Bernsteinaugen“)
Sara Collins (Schriftstellerin, „Das Geständnis der Frannie Langton“)
Yiyun Li (Schrifstellerin, „The Book of Goose“)
Justine Jordan (Chefin des Literatur-Ressorts beim Guardian)
Nitin Sawhney (Musiker und Soundtrack-Komponist, u. a. „The Colour Room“)
Booker Prize 2024: Diese Titel standen auf der Longlist
Nicht nur die Booker-Prize-Endauswahl verdient Aufmerksamkeit. Schon die im Juli veröffentlichte Longlist enthielt spannende Bücher, die als Kommentare aufs Zeitgeschehen, als literarische Innovationen oder poetische Experimente Maßstäbe setzen. Hier erfährst du, was die sieben Titel, die nicht die Shortlist erreicht haben, besonders macht und was die Jury über sie sagte.
„Wild Houses“ von Colin Barrett
Der erste Roman des irisch-kanadischen Autors Colin Barrett ist Außenseiterballade, Gesellschaftsstudie und Krimi in einem. Er erzählt die Geschichte eines schicksalsträchtigen Wochenendes in der irischen Kleinstadt Ballina, an dem sich die Wege des verschuldeten Drogendealers Cillian und der skrupellosen Geldeintreiber Gabe und Sketch Ferdia auf verhängnisvolle Weise kreuzen – der Beginn einer Geiselnahme, eines Rachefeldzugs und einer fieberhaften Rettungsmission.
Colin Barrett wurde 1982 in Kanada geboren, wuchs aber in Irland auf. Als Schriftsteller machte er zunächst durch Kurzgeschichten auf sich aufmerksam. Für seine 2013 veröffentlichte Anthologie „Young Skins“ (in deutscher Übersetzung unter dem Titel „Junge Wölfe“ erschienen) bekam er u. a. den Rooney Prize for Irish Literature. Das Buch enthielt auch den Kurzroman „Calm with Horses“, der 2019 mit Barry Keoghan und Cosmo Jarvis in den Hauptrollen verfilmt wurde.
Das sagte die Booker-Prize-Jury über Wild Houses:
„Ein auf düstere Weise komisches Zeugnis von Frustrationen und Fehltritten in einer irischen Kleinstadt. Eine sich allmählich steigernde Studie von Charakteren und Schicksalen, die gleichzeitig ein packender Thriller ist.“
Irische Literatur im Fokus: Von grüner Idylle bis zur harten Realität
„Headshot“ von Rita Bullwinkel
Die Amerikanerin Rita Bullwinkel lotet in Headshot die Biografien acht junger Frauen aus, die bei einem Boxturnier in Reno im US-Bundesstaat Nevada gegeneinander antreten. Indem die Autorin ungeschönte Beschreibungen der Wettkämpfe mit sensiblen Porträts ihrer Protagonistinnen kreuzt, bürstet sie Klischees übers Frauenboxen gegen den Strich und macht das Lesen zu einer wortwörtlich körperlichen Erfahrung.
Rita Bullwinkel sorgte 2022 mit ihrer Story-Sammlung „Belly Up“ für Aufsehen, für die sie mit dem Whiting Award ausgezeichnet wurde. Neben ihrer Arbeit als Autorin ist sie als Herausgeberin des US-Literaturmagazins Mc Sweeney’s sowie als Professorin für kreatives Schreiben am California College of the Arts tätig. Headshot ist ihr erster Roman. Auf Deutsch ist das Buch unter dem Titel „Schlaglicht“ in der Übersetzung von Christiane Neudecker erschienen.
Das sagte die Booker-Prize-Jury über Headshot:
„Eine mutige und unnachgiebige Beschreibung eines Boxturniers junger Frauen in Nevada und eine tiefgehende Analyse von Identität, Schicksal und familiärer Dynamik.“
Von Glücksgefühlen, Krisen und Erfolgserlebnissen: Sportler-Biografien
„My Friends“ von Hisham Matar
Zwei Freunde, zwei Länder, ein Schicksal. In My Friends erzählt Pulitzer-Preis-Träger Hisham Matar die Geschichte von Khaled und Mustafa, die als junge Studenten aus Benghazi, Libyen, für ein Auslandssemester ins schottische Edinburgh kommen. Noch wissen sie nicht, dass dramatische Ereignisse dazu führen werden, dass sie nicht in ihre Heimat zurückkehren können und radikal von der Welt ihrer Herkunft abgeschnitten werden. Für immer? Als der Arabische Frühling anbricht, stehen die beiden Freunde nach Jahren im Exil vor einer folgenschweren Entscheidung.
Der britisch-libysche Autor Hisham Matar setzte sich in seinen vielfach ausgezeichneten Werken mal autobiografisch, mal fiktional mit seinen libyschen Wurzeln auseinander und schuf mit „Die Geschichte eines Verschwindens“ und „Die Rückkehr“ internationale Bestseller. Für zweiteres bekam er 2017 in Deutschland den Geschwister-Scholl-Preis. My Friends war nach „In the Country of Men“ im Jahr 2006 sein zweites Buch, das es auf die Booker Prize-Longlist schaffte.
Das sagte die Booker-Prize-Jury über My Friends:
„Eine komplexe und kraftvolle Betrachtung dessen, was Freundschaft ausmacht, und eine bewegende Untersuchung darüber, was Exilerfahrungen mit Menschen machen. “
Mehr Romane über die Kraft der Freundschaft: Unsere „Herzensmenschen“-Toplist
„This Strange Eventful History“ von Claire Messud
Claire Messud war eine weitere Wiederholungstäterin unter den diesjährigen Booker Prize-Nominierungen. Mit ihrem New-York-Roman „The Emperor’s Children“ (in deutscher Übersetzung als „Des Kaisers Kinder“ erschienen) stand die Amerikanerin schon 2006 auf der Longlist. In ihrem neuen Buch This Strange Eventful History taucht sie tief ein in die verworrenen Lebenswege der sogenannten „Pieds-Noirs“, also europäischstämmigen Famlien, die in Algerien sozialisiert und infolge des Zweiten Weltkriegs über die ganze Welt verstreut wurden.
Die Chronik der Familie Cassars, die Messud im Roman aufrollt, basiert in Teilen auf ihrer eigenen Familiengeschichte. Ein wahrhaft weltumspannendes Literaturerlebnis, das auf 450 Seiten von Algerien in die USA, nach Kuba, Kanada, Argentinien und Australien bis zurück zu den Ursprüngen führt: nach Frankreich.
Das sagte die Booker-Prize-Jury über This Strange Eventful History:
„Episch im Umfang, aber intim in seinen Details, folgt dieser packende, zeitlose Roman drei Generationen einer französisch-algerischen Familie auf ihren Reisen rund um die Welt.“
Expertinnen erklären Historie: Mehr Bücher von Autorinnen zur Weltgeschichte
„Wandering Stars“ von Tommy Orange
Zu dem Titel Wandering Stars wurde US-Autor Tommy Orange von einem gleichnamigen Portishead-Song inspiriert – ein Trauergesang, der den Ton für dieses gleichsam berührende wie wütende Buches setzt, das vom Sand-Creek-Massaker im Jahr 1864, bei dem amerikanische Soldaten 133 Angehörige der indigenen Cheyenne- und Arapaho-Stämme töteten, bis zu den Folgen einer Massenerschießung indigener Menschen Anfang des 21. Jahrhunderts die Schrecken einer andauernden mörderischen Verfolgung vor Augen führt.
Tommy Orange ist selbst Angehöriger des Cheyenne-und-Arapaho-Stammes in Oklahoma und thematisierte dessen Verfolgung schon in seinem Debüt „There There“. Die deutsche Übersetzung „Dort Dort“ wurde eindrücklich von Christian Brückner eingelesen. Einige Figuren aus „There There“ tauchen auch in Wandering Stars wieder auf.
Das sagte die Booker-Prize-Jury über Wandering Stars:
„Dieses Jahrhunderte umspannende Epos zeichnet ein lebendiges Porträt davon, welche Erfahrungen indigene Menschen in einer Gesellschaft machen, die deren Potenzial viel zu oft verkennt.“
Die Ursprünge der Unterdrückung verstehen: Wichtige Hörbücher zur Geschichte der USA
„Enlightment“ von Sarah Perry
Nach dem Erfolg von „The Essex Serpent“ (auf Deutsch als „Die Schlange von Essex“ erschienen), die mit Claire Danes und Tom Hiddleston in den Hauptrollen zur Serie adaptiert wurde, erkundet Sarah Perry in Enlightment erneut die Mysterien der ostenglischen Grafschaft Essex. Thomas und Grace haben nie über die engen Grenzen ihrer Baptistengemeinde in Aldleigh hinausgedacht. Das ändert sich, als sich Thomas in den Museumsleiter James Bower verliebt. Auf einmal bekommt das stoische Kleinstadtidyll Risse – und damit die Freundschaft von Thomas und Grace. Thomas muss erst den Sternenhimmel für sich entdecken, um sich Grace wieder anzunähern.
Der englische Titel kann sowohl mit „Aufklärung“ als auch mit „Erleuchtung“ übersetzt werden. Beides passt perfekt zu diesem Roman. Enlightment ist ein Text, der ohne Gefühlsduselei zeigt, wie das Zulassen eigener Empfindungen nicht nur den persönlichen Horizont öffnen, sondern buchstäblich den Kosmos erweitern kann.
Das sagte die Booker-Prize-Jury über Enlightment:
„Ein stiller Roman über tief empfundene Freuden, angesiedelt im kleinstädtischen Milieu von Essex – und eine ambitionierte Erkundung des Himmels, der Kometen, des Glaubens, der Geister und der Liebe.“
Zur literarischen Tradition der Sarah Perry vordringen: So düster ist Dark Fantasy
„Playground“ von Richard Powers
Nachdem er sich in seinem Weltbestseller „The Overstory“ (deutscher Titel: „Die Wurzeln des Lebens“) im wörtlichen Sinne mit dem geheimen Leben der Bäume beschäftigte, nimmt sich Pulitzer-Preis-Träger Richard Powers in Playground die gefährdete Schönheit der Ozeane vor. Auf der Pazifikinsel Makatea treffen die Taucherin Evelyne, Künstlerin Ina, Büchernarr Rafi und Computer-Nerd Todd aufeinander. Sie alle sind auf ihre eigene Weise auf der Suche nach Antworten auf die Frage, ob an diesem entlegenen Ort die Rettung der alten Welt gelingen kann oder die Gründung einer neuen anfängt.
Dies war bereits die dritte Booker-Prize-Nominierung für Richard Powers. 2019 war er für „The Overstory“ nominiert, 2021 für „Bewilderment“ (auf Deutsch als „Erstaunen“ erschienen). Die im Oktober erscheinende deutsche Fassung von Playground übersetzt den Titel etwas freier mit „Das große Spiel“.
Das sagte die Booker-Prize-Jury über Playground:
„In diesem beglückenden Roman wappnen sich polynesische Inselbewohner für das Votum über die künstliche Wohninsel eines Millionärs – eine Story, die die Themen Klimawandel und Kolonialismus vereint.“
Richard Powers gewann den Pulitzer-Preis 2019: Erfahre mehr über den Literatur-Oscar
Was den Booker Prize ausmacht: Budget, Renommee und Tradition
Wichtiger als das Preisgeld ist beim Booker das Renommee. Es wird gewährleistet durch die hochqualifizierte Jury, aktive Öffentlichkeitsarbeit und ständige Weiterentwicklung der Marke Booker. Zum Beispiel wurde im Jahr 2004 neben dem Hauptpreis zusätzlich der International Booker Prize etabliert, der seither jährlich im Sommer nichtenglischsprachige Romane auszeichnet, die ins Englische übersetzt wurden.
Was die Tradition angeht, spricht die ununterbrochene 55-jährige Geschichte des Preises ebenso für sich wie die klangvolle Liste derer, die die Auszeichnung bisher bekommen haben – zu denen u. a. Iris Murdoch, Salman Rushdie, Margaret Atwood und Julian Barnes gehören.
Lerne die deutsche Gewinnerin des International Booker Prize kennen: Jenny Erpenbeck im Porträt
Booker Prize 2024: Preisgekrönte Titel bei Audible entdecken
Du bist auf den Geschmack gekommen und willst mehr über Werke erfahren, die den Booker Prize bekommen haben? In der Audible-Kategorie Booker Prize findest du eine große Auswahl ausgezeichneter Titel, die ins Deutsche übersetzt wurden. Die englischsprachigen Originale findest du bei Englische Hörbücher.
Falls du Audible noch nicht ausprobiert hast: Im Probemonat streamst du unbegrenzt tausende von Hörbüchern, Hörspielen und Original Podcasts. Zusätzlich erhältst du einen kostenlosen Titel, den du für immer behalten kannst.